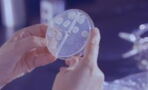
Tuberculosis: This disease from the past could be making a comeback due to COVID

Since September, reports of rapidly increasing numbers have been accumulating. This eye disease is currently spreading faster than ever in Asia.
Discover our latest podcast
Hundreds of thousands of people infected in record time
According to various media outlets, including Newsroom citing a report from Vietnam, current conjunctivitis is spreading rapidly in several Asian countries - Pakistan is reported to have already reported over 400,000 cases in September alone.
Currently, an adenovirus is suspected to be the causative agent: These persistent viruses are said to be to blame for up to 75% of the current illnesses in Asia. For this reason, thousands of schools have already been closed in India, among other places, in order to interrupt the mass infection.
Read more:Shingles vaccine: Over 1 million people are eligible to get jabbed, should you get it?
Climate change to blame?
According to Pakistani doctors, it cannot be ruled out that climate change plays a role in the rapid spread of the disease. The monsoon season has been much longer than in the past - which increases the risk of infection due to the high humidity, because the viruses can develop better and faster.
In addition, globalization could lead to the aggressive conjunctivitis wave also soon affecting Germany and Europe - especially in the local winter months, countries such as Vietnam are popular travel destinations.
Read more:Monkeypox: WHO recommends Covid-19 measures to contain the virus
The disease is unpleasant, but usually not dangerous
Those who have already booked their vacation and do not want to cancel it, however, do not automatically have to fear the worst. According to the Federal Center for Health Education, infections can largely be avoided if you stick to the classic hygiene rules. For example, wash your hands regularly and avoid rubbing your eyes with your fingers.
There were isolated reports of young patients in Vietnam who had suffered bleeding in the eyes - but this was rather the exception. All in all, conjunctivitis is unpleasant and highly contagious, but not dangerous.
Read more:Expert warns 'there are signals' that second pandemic is possible, and it's not Covid
This article has been translated from Gentside DE.
Sources used:
Newsweek: Pink-Eye Epidemic Impacts Hundreds of Thousands of People
Fitbook: IN ASIEN: Bindehautentzündungs-Epidemie! Tausende stecken sich täglich an